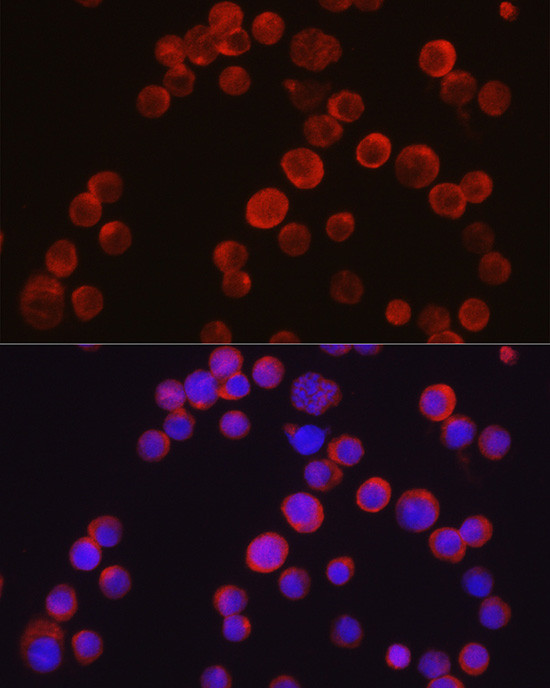
TEC Antibody in Immunocytochemistry (ICC/IF)

Search
Invitrogen
TEC Polyclonal Antibody
{{$productOrderCtrl.translations['antibody.pdp.commerceCard.promotion.promotions']}}
{{$productOrderCtrl.translations['antibody.pdp.commerceCard.promotion.viewpromo']}}
{{$productOrderCtrl.translations['antibody.pdp.commerceCard.promotion.promocode']}}: {{promo.promoCode}} {{promo.promoTitle}} {{promo.promoDescription}}. {{$productOrderCtrl.translations['antibody.pdp.commerceCard.promotion.learnmore']}}






Please note: We are reviewing Western blot images included in the antibody testing data in our catalog, including those provided by third parties. Unless expressly labeled or annotated as “raw-unedited”, Western blot images included in the antibody testing data in our catalog may have been edited, optimized or otherwise adjusted for presentation.
产品信息
PA5-116493
种属反应
宿主/亚型
分类
类型
抗原
偶联物
形式
浓度
规格
纯化类型
保存液
内含物
保存条件
运输条件
RRID
产品详细信息
Positive Samples: HeLa, Mouse liver, Mouse thymus, Mouse spleen, Rat liver
Immunogen sequence: MNFNTILEEI LIKRSQQKKK TSPLNYKERL FVLTKSMLTY YEGRAEKKYR KGFIDVSKIK CVEIVKNDDG VIPCQNKYPF QVVHDANTLY IFAPSPQSRD LWVKKLKEEI KNNNNIMIKY HPKFWTDGSY QCCRQTEKLA PGCEKYNLFE SSIRKALPPA PETKKRRPPP PIPLEEEDNS EEIVVAMYDF QAAEGHDLRL ERGQEYLILE KNDVHWWRAR DKYGNEGYIP SNYVTGKKSN NLDQYEWYCR NMNRSKAEQL LRSEDKEGGF MVRDSSQPGL
靶标信息
TEC is a non-receptor protein-tyrosine kinase containing a pleckstrin homology domain and is highly expressed in many hematopoietic cell lines. They are also key players in the regulation of the immune functions. Tec kinase is an integral component of T cell signaling and has a distinct role in T cell activation. This gene may be associated with myelodysplastic syndrome.
仅用于科研。不用于诊断过程。未经明确授权不得转售。
篇参考文献 (0)
生物信息学
蛋白别名: cytoplasmic tyrosine kinase, Dscr28C related; MGC126760; MGC126762; Tyrosine-protein kinase Tec
基因别名: PSCTK4; TEC
UniProt ID: (Mouse) P24604
Entrez Gene ID: (Rat) 84492, (Mouse) 21682